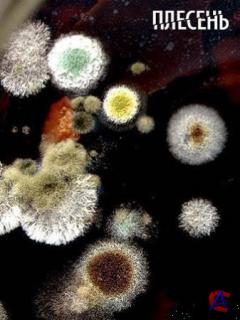

|
|
Видео
Плесень
добавлено: 05.07.2009 10:19:00
|
Кто добавил:
Lynch
 УполномоченныйРейтинг: 79656
УполномоченныйРейтинг: 79656    
|

|
Рейтинг
|
|
|
 |
|
|
|
Категория:
|
Видео
|
|
Подкатегория: |
Документальный |
|
Год выпуска:
|
2008 |
|
Страна:
|
Россия |
|
Режиссёр:
|
Дмитрий Васильев |
|
В ролях:
|
Наталья Новикова, Жан Поль Латже, Франсуаза Дромер, Перл Лаперла, Сергей Сидоренко, Светлана Чубатова, Адин Штейнзальц |
|
Размер: |
2795 МБ |
|
|
Описание:
Качество: DVDRip
Видео кодек: XviD 1739 Kbps, 25.0 fps, разрешение 720*416 (16:9), XVID
Аудио кодек: MP3 234 Kbps, 48000 Hz, 2 канала, Lame MP3
Качество: DVDRip
Видео кодек: Xvid 720x416 25.00fps
Аудио кодек: MPEG Audio Layer 3 48000Hz stereo 234kbps
Продолжительность: 01:39:09
Перевод: Не требуется
Описание: В эфире Первого канала 1 февраля состоится премьера документального фильма «Плесень». Нетрудно догадаться – он покажет «подноготную» самой распространенной и самой древней на Земле части живой природы. Что это - восхваление или страшилка? Сняли фильм создатели сенсационных проектов «Осторожно, еда» и «Великая тайна воды», получивших награды и «почетные звания», в том числе и «ТЭФИ-2006».
"Она появилась на Земле 200 миллионов лет назад. Она убивает и спасает от смерти. Ее называют "хлебом дьявола" и "плевком Бога". Она сказочно красива, но вызывает отвращение", - это цитата из нового масштабного документального проекта "Плесень", который в самое ближайшее время выйдет на Первом канале. Красочные сравнения и образы, яркие кадры, сложные компьютерные инсталляции демонстрируют зрителю отнюдь не фантастическое и невиданное существо, а то, что сопровождает человека от рождения и до смерти - плесень. Создатели картины – авторы нашумевших проектов "Осторожно, еда" и "Великая тайна воды". "Это была моя личная просьба, потому что я очень люблю соленые огурцы, - рассказал перед премьерой заместитель генерального директора по общественно-политическому вещанию ОАО "Первый канал" Олег Вольнов. - Я лично просил авторов ответить мне на вопрос: если на них появилась плесень, можно ли помыть огурец и его съесть? Авторы ответили: "Нельзя" При этом я лично настаивал, чтобы акцент в фильме был сделан на бытовую применимость знаний". В фильме рассказывается о том, что плесень вездесуща, а благоприятные условия для ее размножения создает сам человек – устанавливает стеклопакеты, кондиционеры и фильтры для очистки воды.
В документальном рассказе приведены мнения множества выдающихся ученых из университетов и научных институтов России, Франции, Великобритании и США. В фильме исторические факты иллюстрируют полномасштабные постановочные сцены с участием актеров.
|
|
|
|

|
Прочие скриншоты - скрыть
Прочие скриншоты - показать
|
|
Комментарии:
07.10.2010 23:26:38
LonelySoul
|
|
Лучше BBC посмотреть чем всю эту теоретику)
|
|
|
|
Оставлять комментарии могут только зарегистрированые пользователи
|
|




 Сергей Бодров. Где ты, брат?
Сергей Бодров. Где ты, брат? NG - Тайна города Близнецов / Mengele`s Twins
NG - Тайна города Близнецов / Mengele`s Twins Русское Сопротивление
Русское Сопротивление HISTORY - Вселенная / Universe, The (1 сезон)
HISTORY - Вселенная / Universe, The (1 сезон) Тачку на прокачку / Pimp My Ride (1-Й СЕЗОН)
Тачку на прокачку / Pimp My Ride (1-Й СЕЗОН)